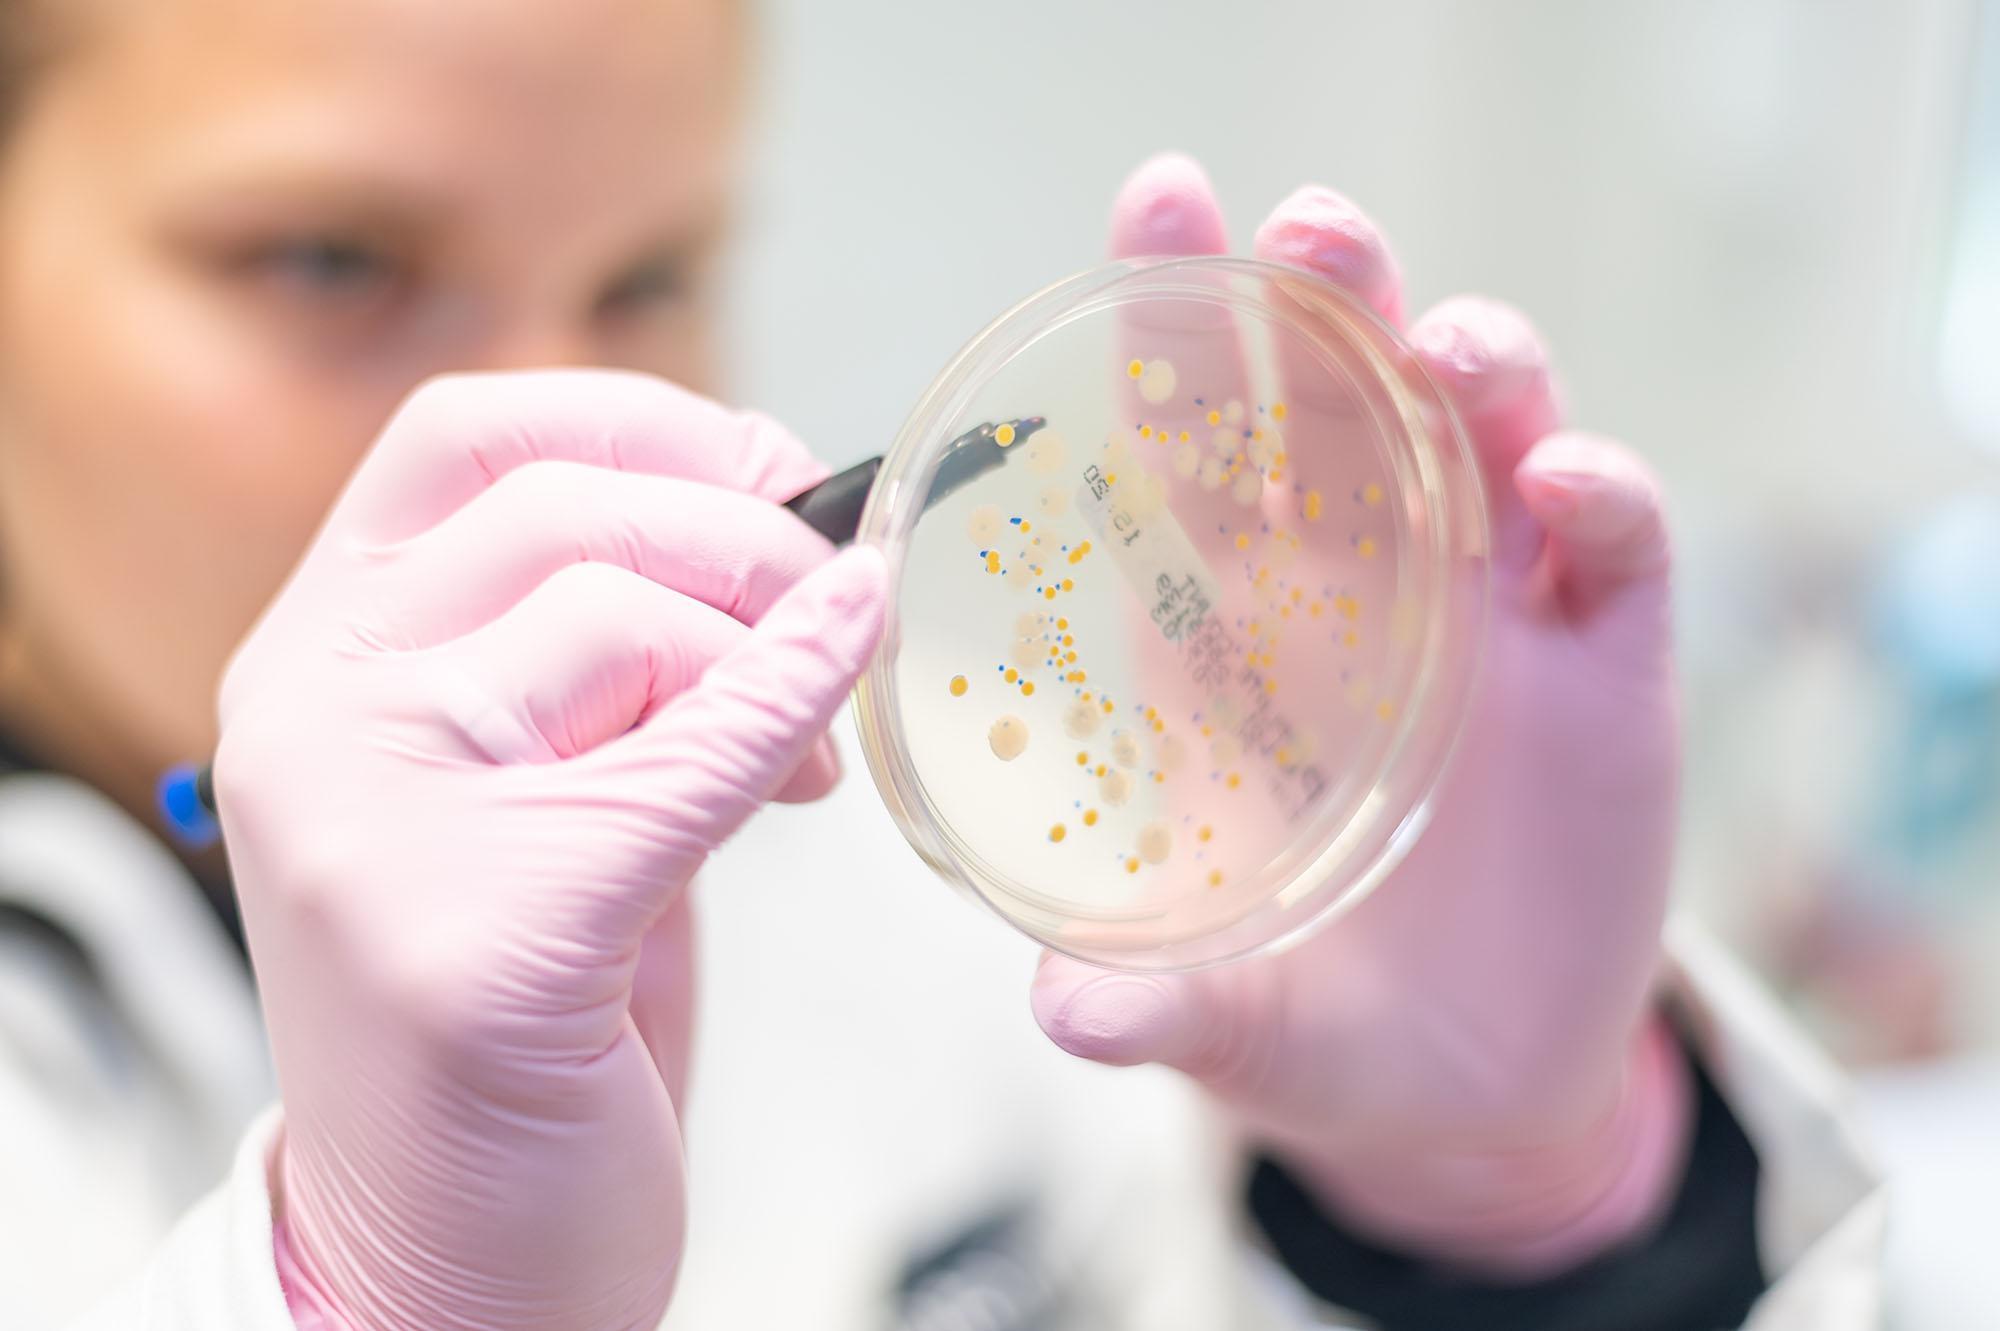

112 UCAS points
UCAS Points | 112 UCAS points |
GCE A Level | Typical offer BCC-BBC, including one of the following subjects: |
BTEC | BTEC Extended Diploma (Applied Science/Animal Management): DMM |
International Baccalaureate | 26 points including 5 in Biology or Chemistry |
Irish/Scottish Highers | Irish Highers: H3, H3, H3, H3, H4 including H3 in Biology or Chemistry Scottish Highers: BBBB, including Biology or Chemistry |
Access requirements | Access to HE Diploma (Science): to include 45 credits at Level 3, 30 of which must be at Merit |
T Level | T Level (Science): Merit |
OCR Cambridge Technicals | OCR Extended Diploma (Applied Science): DMM |
Extra Requirements | The Welsh Baccalaureate (core) and A Level General Studies will be recognised in our offer. We will also consider a combination of A Levels and BTECs/OCRs. If you are interested in our course but your current areas of study or combination of qualifications are not covered by our admissions criteria listed, please email admissions@chester.ac.uk to discuss whether your subjects or prior experience meet the required content in sufficient detail. |
Occupational Health | An Occupational Health check is required |
Students from outside the UK are expected to hold qualifications broadly equivalent to UK standards - typically A Level for undergraduate study.
To help you interpret these equivalents, please select your country/region of residence. This will provide details on equivalent entry requirements, as well as information about local representatives, events, and key contacts.
We accept a wide range of qualifications and assess all applications on an individual basis. Relevant work experience may also be taken into consideration where appropriate.
For more information on English entry requirements, including accepted qualifications, please visit International Entry Requirements.
English Language Requirements
IELTS | Students from countries outside the UK applying for an undergraduate degree are expected to have IELTS Academic 6.0 (minimum 5.5 in each band). More information can be found here: https://www.chester.ac.uk/international/how-to-apply/entry-requirements/ |
Occupational Health | An Occupational Health check is required |
72 UCAS points
UCAS Points | 72 UCAS points |
GCE A Level | 72 points from GCE A Levels, including grade D in A Level Biology, Chemistry or Applied Science |
BTEC | BTEC Extended Diploma (Applied Science/Animal Management): MMP |
International Baccalaureate | 24 points, including 4 in HL Biology or Chemistry |
Irish/Scottish Highers | Irish Highers: H4 H4 H4 H4 H4, including Biology or Chemistry Scottish Highers: CCDD, including Biology or Chemistry |
Access requirements | Access to HE Diploma (Science): Pass overall |
T Level | T Level (Science): Pass (D or E on the core) |
OCR Cambridge Technicals | OCR Extended Diploma (Applied Science): MMP |
Extra Requirements | If you are a mature student (21 or over) and have been out of education for a while or do not have experience or qualifications at Level 3 (equivalent to A Levels), then our Foundation Year courses will help you to develop the skills and knowledge you will need to succeed in your chosen degree. The Welsh Baccalaureate (core) and A Level General Studies will be recognised in our offer. We will also consider a combination of A Levels and BTECs/OCRs. If you are interested in our course but your current areas of study or combination of qualifications are not covered by our admissions criteria listed, please email admissions@chester.ac.uk to discuss whether your subjects or prior experience meet the required content in sufficient detail. |

-Chloe-(student)-May-2023.jpg)
.jpg)
.jpg)











.png)
.jpg)





